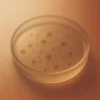
Placa de petri Microbiology PT scheme | ILT - Proficiency Testing provider

ILT-MC-013
Microbiological determination Escherichia Coli – Qualitative
Determinación: Escherichia Coli Qualitative: Positive/Negative growth tests. (Food testing – Media testing – Quality control
Water testing – Pharmaceutical testing)
Método: Nutrient agar or nutrient broth.(Temperature: 37°C, 24 hs, Aerobic)